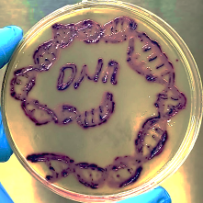
Profile picture

Dr. Nisar Ahmad (DNA)
Doctorate
-
Assistant ProfessorUniversity of SwatSwat, Pakistan
